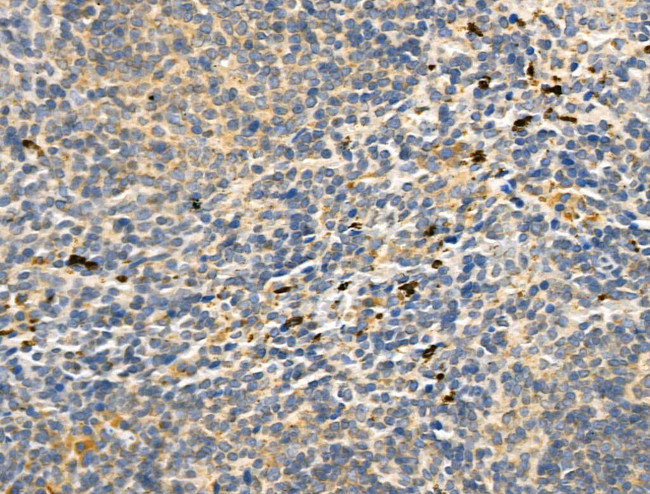
CD83 Antibody in Immunohistochemistry (Paraffin) (IHC (P))

Search
Invitrogen
CD83 Polyclonal Antibody
{{$productOrderCtrl.translations['antibody.pdp.commerceCard.promotion.promotions']}}
{{$productOrderCtrl.translations['antibody.pdp.commerceCard.promotion.viewpromo']}}
{{$productOrderCtrl.translations['antibody.pdp.commerceCard.promotion.promocode']}}: {{promo.promoCode}} {{promo.promoTitle}} {{promo.promoDescription}}. {{$productOrderCtrl.translations['antibody.pdp.commerceCard.promotion.learnmore']}}
图: 1 / 2
CD83 Antibody (PA5-114994) in IHC (P)


Please note: We are reviewing Western blot images included in the antibody testing data in our catalog, including those provided by third parties. Unless expressly labeled or annotated as “raw-unedited”, Western blot images included in the antibody testing data in our catalog may have been edited, optimized or otherwise adjusted for presentation.
产品信息
PA5-114994
种属反应
宿主/亚型
分类
类型
抗原
偶联物
形式
浓度
规格
纯化类型
保存液
内含物
保存条件
运输条件
RRID
产品详细信息
Antibody detects endogenous levels of total CD83.
靶标信息
CD83 cell surface antigen is a 40-45kD glycoprotein expressed by peripheral blood dendritic cells. Peripheral lymphocytes can be induced to express very low levels of CD83 after culture in agents such as Con A or PHA. In immunohistology, CD83 is shown to be expressed strongly by interfollicular interdigitating reticulum cells and more weakly by cells within germinal centres. CD83 is also expressed by Langerhan's cells in the skin. The CD83 antigen is a 186-amino-acid single-chain glycoprotein and this molecule is a member of the immunoglobulin superfamily that is composed of an extracellular V-type Ig-like single domain, a transmembrane region, and a short, 40-amino-acid cytoplasmic tail. CD83 antigen undergoes extensive post-translational glycosylation, since the determined Mr is twice the predicted size of the core protein. However, CD83+ cells have a unique cell surface immuno-phenotype that does not correlate with that of T cells, B cells, NK cells, or cells of the myelomonocytic lineage. CD83+ cells coexpress the highest levels of MHC class II molecules, when compared with other leucocyte lineages. They also co-express T cell markers (CD2, CD5), B cell markers (CD40, CD78), myeloid cell markers (CD13, CD33, CD36), cytokine receptors as well as other cell surface molecules. Diseases associated with CD83 dysfunction include plague and Rift Valley Fever.
仅用于科研。不用于诊断过程。未经明确授权不得转售。
篇参考文献 (0)
生物信息学
蛋白别名: B-cell activation protein; CD antigen CD83; CD83; CD83 antigen; Cell surface protein HB15; hCD83; mCD83
基因别名: CD83
UniProt ID: (Mouse) O88324
Entrez Gene ID: (Rat) 361226, (Mouse) 12522